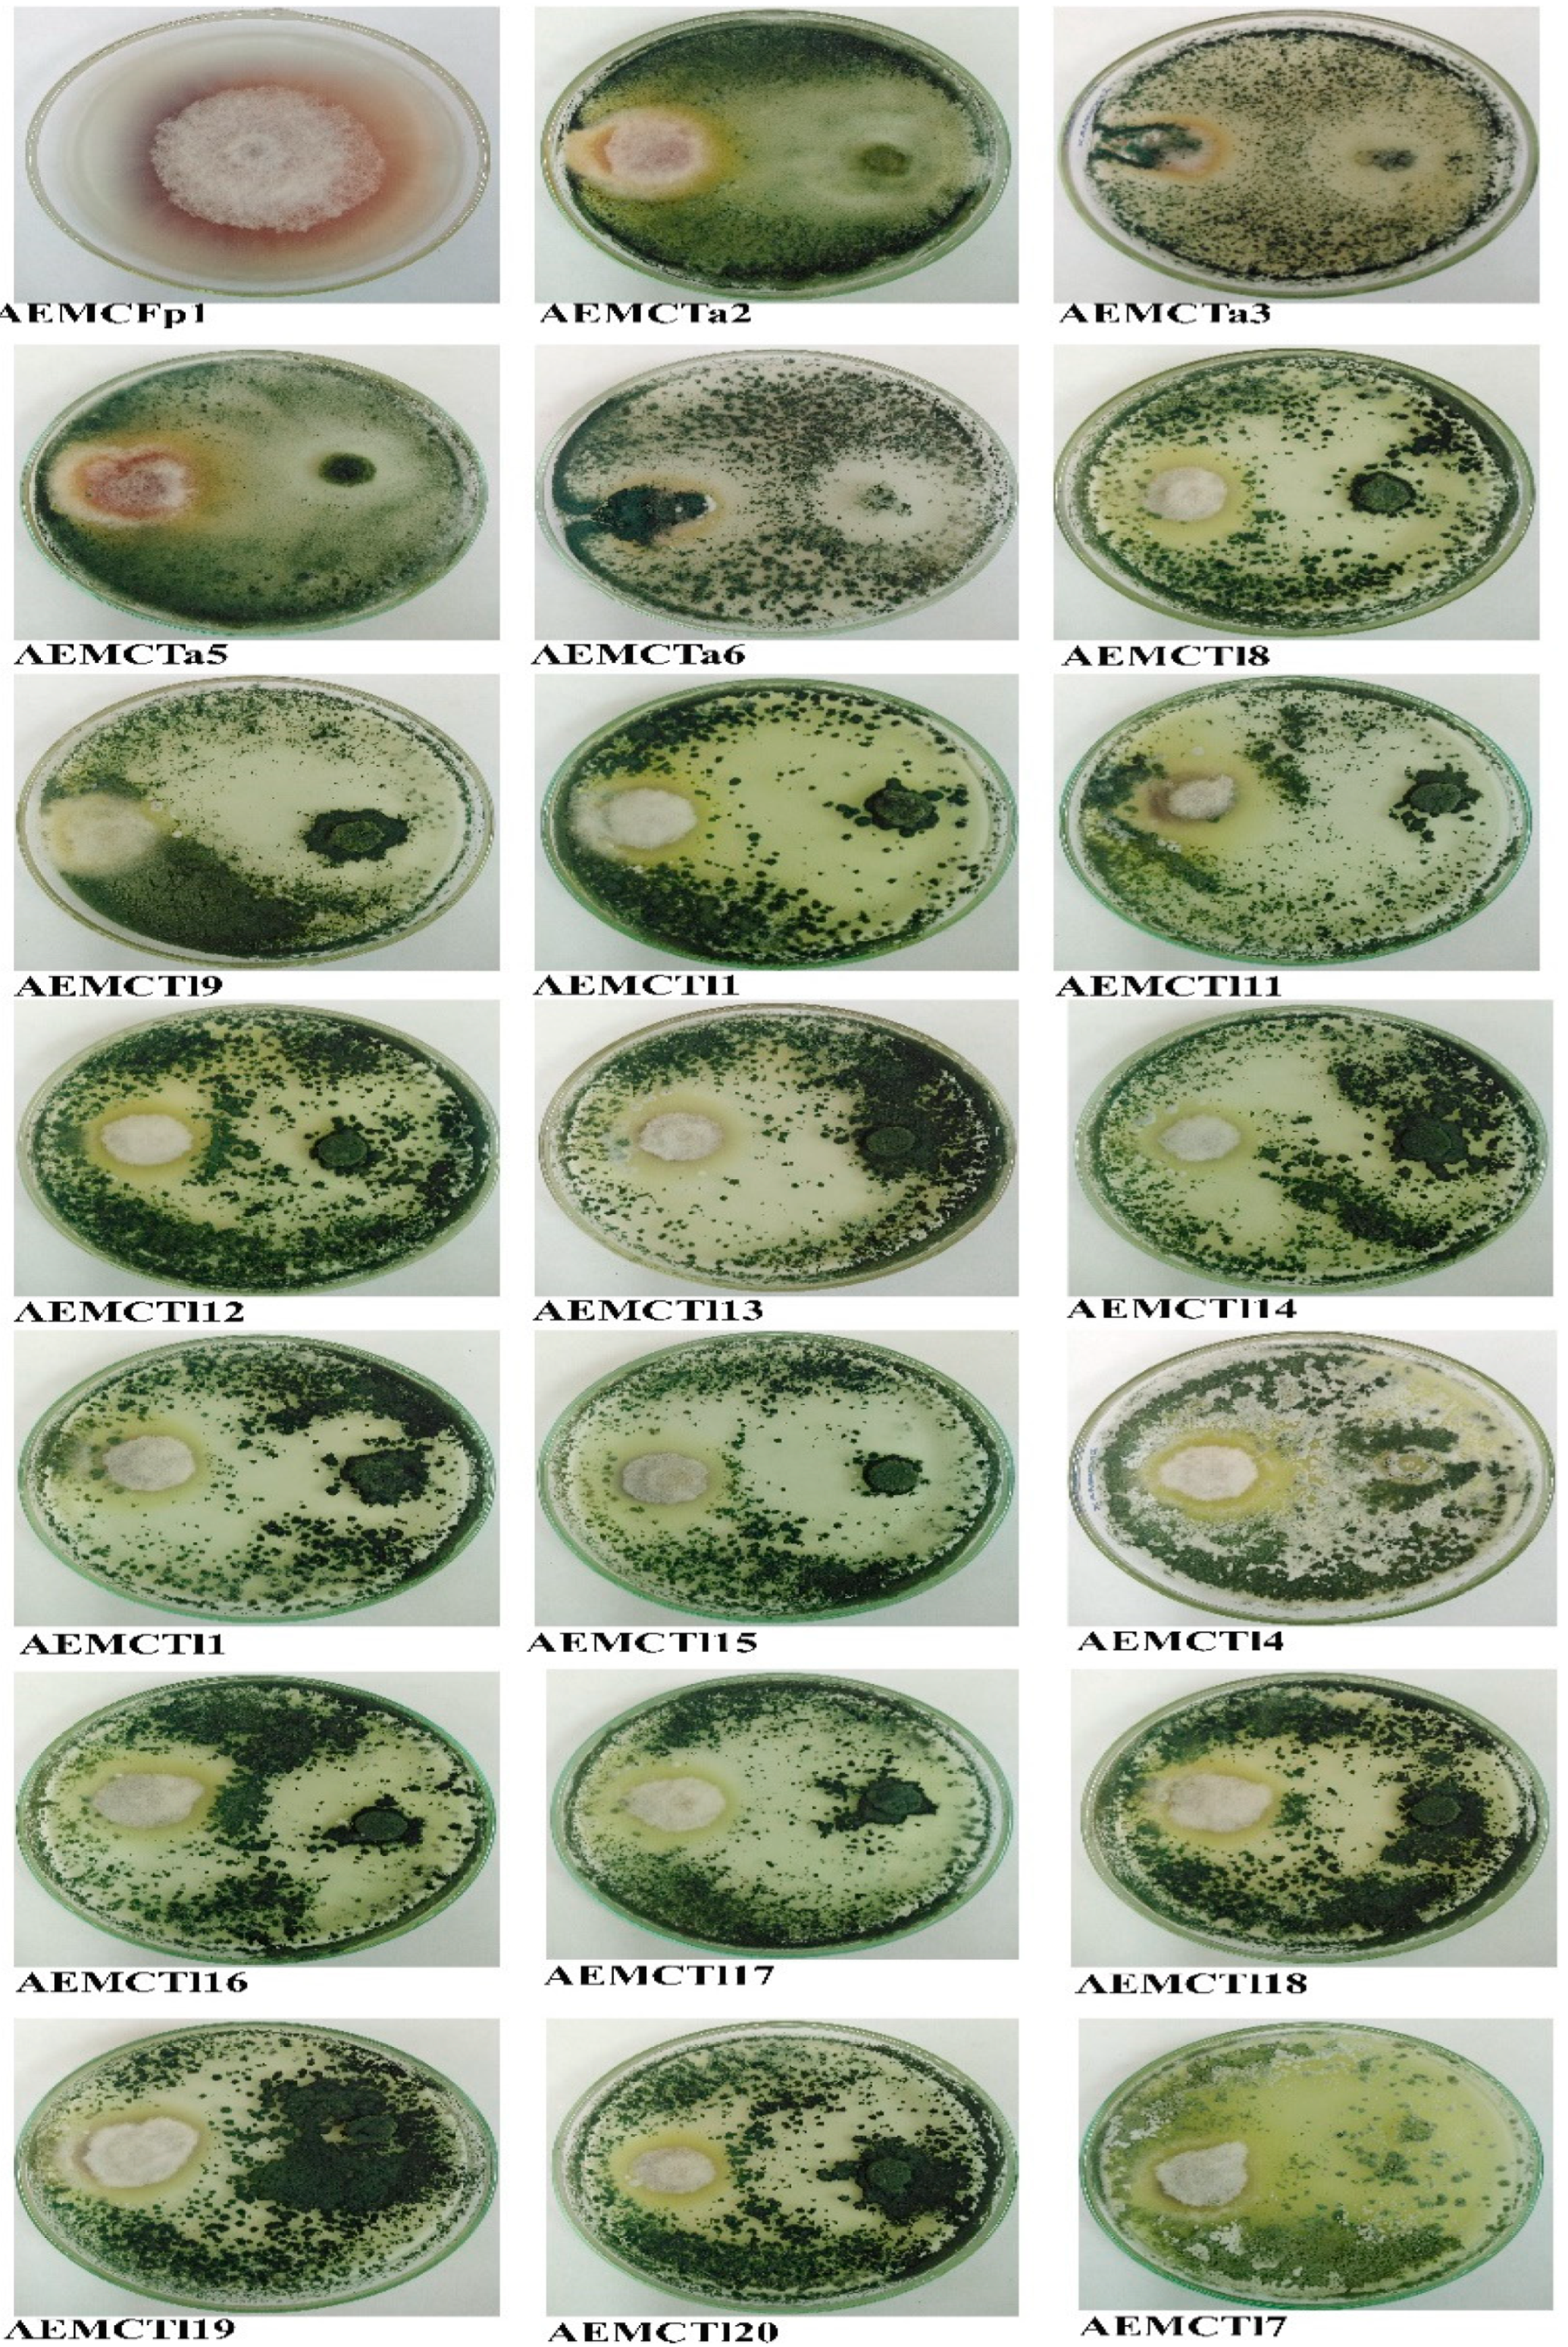

Identification of Trichoderma spp., Their Biomanagement Against Fusarium proliferatum, and Growth Promotion of Zea mays
Abstract
1. Introduction
2. Materials and Methods
2.1. Sample Collection
2.2. Isolation of Trichoderma and Fusarium proliferatum
2.3. Identification of Trichoderma Isolates
2.4. DNA Extraction, PCR Amplification, and Sequencing Analysis
2.5. In Vitro Evaluation of Trichoderma Antagonists Against Fusarium proliferatum
2.6. Greenhouse Experiment of Trichoderma on Maize Plants
2.6.1. Preparation of Fungal Inoculum
2.6.2. Plant Treatments and Growth Conditions
2.7. Gas Chromatography–Mass Spectrometry (GC-MS) Analysis of Secondary Metabolites Produced by T. afroharzianum AEMCTa3 and AEMCTa6
2.8. Root Preparation and Histological Observations
2.9. Statistical Analysis
3. Results
3.1. Morphological Identification of Trichoderma Isolates
3.2. Molecular Identification of Trichoderma Isolates
3.3. Antagonism Efficiency of Trichoderma Species
3.4. Cultivation of Maize Plants Grown in Soil Inoculated with Fusarium proliferatum and Phytoremediation Using Trichoderma Strains
3.4.1. Disease Suppression in Maize by T. afroharzianum
3.4.2. Fresh and Dry Weights and Lengths of Maize Shoots and Roots
3.4.3. Photosynthetic Pigments of Zea mays Plants
3.5. Secondary Metabolites Produced by T. afroharzianum AEMCTa3 and AEMCTa6
3.6. Histological Observations of Zea mays Roots
4. Discussion
Author Contributions
Funding
Institutional Review Board Statement
Informed Consent Statement
Data Availability Statement
Conflicts of Interest
References
- Tiru, Z.; Mandal, P.; Chakraborty, A.P.; Pal, A.; Sadhukhan, S. Management through sustainable approach. In Fusarium: An Overview of the Genus; IntechOpen: London, UK, 2022; Volume 61. [Google Scholar] [CrossRef]
- Lian, H.; Li, R.; Ma, G.; Zhao, Z.; Zhang, T.; Li, M. The effect of Trichoderma harzianum agents on physiological-biochemical characteristics of cucumber and the control effect against Fusarium wilt. Sci. Rep. 2023, 13, 17606. [Google Scholar] [CrossRef]
- Persoon, C.H. Neuer Versuch einer systematischen Einteilung der Schwämme. Racodium Römer’s Neues Mag. Bot. 1794, 1, 123. [Google Scholar]
- Zhao, R.; Chen, K.Y.; Mao, L.J.; Zhang, C.L. Eleven new species of Trichoderma (Hypocreaceae, Hypocreales) from China. Mycology 2024, 16, 180–209. [Google Scholar] [CrossRef]
- Jaklitsch, W.M. European species of Hypocrea Part I. The green-spored species. Stud. Mycol. 2009, 63, 1–91. [Google Scholar] [CrossRef]
- Chaverri, P.; Branco-Rocha, F.; Jaklitsch, W.; Gazis, R.; Degenkolb, T.; Samuels, G.J. Systematics of the Trichoderma harzianum species complex and the re-identification of commercial biocontrol strains. Mycologia 2015, 107, 558–590. [Google Scholar] [CrossRef] [PubMed]
- Samuels, G.J.; Ismaiel, A.; Mulaw, T.B.; Szakacs, G.; Druzhinina, I.S.; Kubicek, C.P.; Jaklitsch, W.M. The Longibrachiatum Clade of Trichoderma: A revision with new species. Fungal Divers. 2012, 55, 77–108. [Google Scholar] [CrossRef] [PubMed]
- Eslahi, N.; Kowsari, M.; Zamani, M.R.; Motallebi, M. Correlation study between biochemical and molecular pathways of Trichoderma harzianum recombinant strains on plant growth and health. J. Plant Growth Regul. 2022, 41, 1561–1577. [Google Scholar] [CrossRef]
- Stenberg, J.A.; Sundh, I.; Becher, P.G.; Björkman, C.; Dubey, M.; Egan, P.A.; Friberg, H.; Gil, J.F.; Jensen, D.F.; Jonsson, M.; et al. When is it biological control? A framework of definitions, mechanisms, and classifications. J. Pest Sci. 2021, 94, 665–676. [Google Scholar] [CrossRef]
- Win, T.T.; Bo, B.; Malec, P.; Khan, S.; Fu, P. Newly isolated strain of Trichoderma asperellum from disease suppressive soil is a potential bio-control agent to suppress Fusarium soil borne fungal phytopathogens. J. Plant Pathol. 2021, 103, 549–561. [Google Scholar] [CrossRef]
- Hasna, M.K.; Paul, N.R.; Haque, M.M.; Bir, M.S.H.; Ali, M.A.; Chong, K.P. Biocontrol efficacy of Trichoderma asperellum against fusarium wilt in tomato plants by induction of the host defense genes. Discov. Plants 2025, 2, 1–9. [Google Scholar] [CrossRef]
- Köhl, J.; Kolnaar, R.; Ravensberg, J. Mode of action of microbial biological control agents against plant diseases: Relevance beyond efficacy. Front. Plant Sci. 2019, 10, 845. [Google Scholar] [CrossRef]
- Yao, X.; Guo, H.; Zhang, K.; Zhao, M.; Ruan, J.; Chen, J. Trichoderma and its role in biological control of plant fungal and nematode disease. Front. Microbiol. 2023, 14, 1160551. [Google Scholar] [CrossRef] [PubMed]
- Bharti, L.; Yadav, K.; Kumar Chaubey, A. Trichoderma spp.: Approach for bio-control agent. In Challenges in Plant Disease Detection and Recent Advancements; IntechOpen: London, UK, 2024; pp. 1–30. [Google Scholar] [CrossRef]
- Zin, N.A.; Badaluddin, N.A. Biological functions of Trichoderma spp. for agriculture applications. Ann. Agric. Sci. 2020, 65, 168–178. [Google Scholar] [CrossRef]
- Pozo, M.I.; Herrero, B.; Martín-García, J.; Santamaría, Ó.; Poveda, J. Evaluating potential side effects of Trichoderma as biocontrol agent: A two-edges sword? Curr. Opin. Environ. Sci. Health 2024, 41, 100566. [Google Scholar] [CrossRef]
- Kubiak, A.; Wolna-Maruwka, A.; Pilarska, A.A.; Niewiadomska, A.; Piotrowska-Cyplik, A. Fungi of the Trichoderma genus: Future perspectives of benefits in sustainable agriculture. Appl. Sci. 2023, 13, 6434. [Google Scholar] [CrossRef]
- Christensen, C.M. Influence of small differences in moisture content upon the invasion of hard red winter wheat by Aspergillus restrictus and A. repens. Cereal Chem. 1963, 40, 385–395. [Google Scholar]
- Siddiquee, S. Practical Handbook of the Biology and Molecular Diversity of Trichoderma Species from Tropical Regions; Fungal Biology; Springer: Cham, Switzerland, 2017. [Google Scholar] [CrossRef]
- Gorczyca, A.; Oleksy, A.; Gala-Czekaj, D.; Urbaniak, M.; Laskowska, M.; Waskiewicz, A.; Stepien, L. Fusarium head blight incidence and mycotoxin accumulation in three durum wheat cultivars in relation to sowing date and density. Sci. Nat. 2018, 105, 1–11. [Google Scholar] [CrossRef]
- White, T.J.; Bruns, T.; Lee, S.J.; Taylor, J. Amplification and direct sequencing of fungal ribosomal RNA genes for phylogenetics. PCR Protoc. 1990, 18, 315–322. [Google Scholar]
- Carbone, I.; Kohn, L.M.A. A method for Designing Primer Sets for Speciation Studies in Filamentous Ascomycetes. Mycologia 1999, 91, 553–556. [Google Scholar] [CrossRef]
- Samuels, G.J.; Dodd, S.L.; Gams, W.; Castlebury, L.A.; Petrini, O. Trichoderma Species Associated with the Green Mold Epidemic of Commercially Grown Agaricus bisporus. Mycologia 2002, 94, 146–170. [Google Scholar] [CrossRef]
- Tomczyk, L.; Stepien, L.; Urbaniak, M.; Szablewski, T.; Cegielska-Radziejewska, R.; Stuper-Szablewska, K. Characterisation of the mycobiota on the shell surface of table eggs acquired from Di_erent Egg-Laying Hen Breeding Systems. Toxins 2018, 10, 293. [Google Scholar] [CrossRef] [PubMed]
- Meintjes, P.; Duran1, C.; Kearse, M.; Moir, R.; Wilson, A.; Stones-Havas, S.; Cheung, M.; Sturrock, S.; Buxton, S.; Cooper, A.; et al. Geneious Basic: An integrated and extendable desktop software platform for the organization and analysis of sequence data. Bioinform. Adv. Access 2012, 27, 1–2. [Google Scholar] [CrossRef]
- Sneath, P.H.A.; Sokal, R.R. Numerical Taxonomy; Freeman: San Francisco, CA, USA, 1973; pp. 400–408. [Google Scholar]
- Jukes, T.H.; Cantor, C.R. Evolution of protein molecules. In Mammalian Protein Metabolism, III; Munro, H.N., Ed.; Academic Press: New York, NY, USA, 1969; pp. 21–132. [Google Scholar]
- Van de Peer, Y.; de Wachter, R. Treecon for Windows: A software package for the construction and drawing of evolutionary trees for the Microsoft Windows environment. Comput. Appl. Biosci. 1994, 10, 569–570. [Google Scholar] [CrossRef] [PubMed]
- Imtiaj, A.; Lee, T.S. Antagonistic effect of three Trichoderma species on the Alternaria porri pathogen of onion blotch. World J. Agric. Sci. 2008, 4, 13–17. [Google Scholar]
- Abou Alhamed, M.F.; Shebany, Y.M. Endophytic Chaetomium globosum enhances maize seedling copper stress tolerance. Plant Biol. 2012, 14, 859–863. [Google Scholar] [CrossRef]
- Gherbawy, Y.A.; El-tayeb, M.A.; Maghraby, T.A.; Shebany, Y.M.; El-deeb, B.A. Response of antioxidant enzymes and some metabolic activities in wheat to Fusarium spp. infections. Acta Agron. Hung. 2012, 60, 319–333. [Google Scholar] [CrossRef]
- Bayoub, K.; Baibai, T.; Mountassif, D.; Retmane, A.; Soukri, A. Antibacterial activities of the crude ethanol extracts of medicinal plants against Listeria monocytogenes and some other pathogenic strains. Afr. J. Biotechnol. 2010, 9, 4251–4258. [Google Scholar]
- Livingston, D.P., III; Tuong, T.D.; Haigler, C.H.; Avci, U.T.K.U.; Tallury, S.P. Rapid microwave processing of winter cereals for histology allows identification of separate zones of freezing injury in the crown. Crop Sci. 2009, 49, 1837–1842. [Google Scholar] [CrossRef]
- Gezgin, Y.; Güralp, G.; Barlas, A.B.; Eltem, R. Morphological and molecular identification of trichoderma isolates used as biocontrol agents by DNA barcoding. Eur. J. Biol. 2023, 82, 59–69. [Google Scholar] [CrossRef]
- Iqbal, S.; Ashfaq, M.; Malik, A.H.; Inam-ul-Haq, M.; Khan, K.S. Morpho-molecular characterization of trichoderma isolates from rhizospheric soils of vegetables in Pakistan. Int. J. Phytopathol. 2022, 11, 253–266. [Google Scholar] [CrossRef]
- Urbaniak, M.; Waśkiewicz, A.; Koczyk, G.; Błaszczyk, L.; Stępień, Ł. Divergence of beauvericin synthase gene among Fusarium and trichoderma species. J. Fungi 2020, 6, 288. [Google Scholar] [CrossRef]
- O’Donnell, K.; Ward, T.J.; Geiser, D.M.; Kistler, H.C.; Aoki, T. Genealogical concordance between the mating type locus and seven other nuclear genes supports formal recognition of nine phylogenetically distinct species within the Fusarium graminearum clade. Fungal Genet. Biol. 2004, 41, 600–623. [Google Scholar] [CrossRef]
- Blaszczyk, L.; Popiel, D.; Chelkowski, J.; Koczyk, G.; Samuels, G.J.; Sobieralski, K.; Siwulski, M. Species diversity of Trichoderma in Poland. J. Appl. Genet. 2011, 52, 233–243. [Google Scholar] [CrossRef]
- Chen, J.; Zhou, L.; Din, I.U.; Arafat, Y.; Li, Q.; Wang, J.; Wu, T.; Wu, L.; Wu, H.; Qin, X.; et al. Antagonistic activity of Trichoderma spp. against Fusarium oxysporum in rhizosphere of Radix pseudostellariae triggers the expression of host defense genes and improves its growth under long-term monoculture system. Front. Microbiol. 2021, 12, 579920. [Google Scholar] [CrossRef]
- Elshahawy, I.E.; Marrez, D.A. Antagonistic activity of Trichoderma asperellum against Fusarium species, chemical profile and their efficacy for management of Fusarium-root rot disease in dry bean. Pest Manag. Sci. 2024, 80, 1153–1167. [Google Scholar] [CrossRef]
- Carvalho, D.D.C.; de Mello, S.C.M.; Martins, I.; Lobo, M., Jr. Biological control of Fusarium wilt on common beans by in-furrow application of Trichoderma harzianum. Trop. Plant Pathol. 2015, 40, 375–381. [Google Scholar] [CrossRef]
- Degani, O.; Dor, S. Trichoderma biological control to protect sensitive maize hybrids against late wilt disease in the field. J. Fungi 2021, 7, 315. [Google Scholar] [CrossRef] [PubMed]
- Mei, L.; Guang-shu, M.; Hua, L.; Xiao-lin, S.; Ying, T.; Wen-kun, H.; Jie, M.; Xiliang, J. The effects of Trichoderma on preventing cucumber Fusarium wilt and regulating cucumber physiology. J. Integr. Agric. 2019, 18, 607–617. [Google Scholar] [CrossRef]
- Mazungunye, H.T.; Ngadze, E. Evaluation of Trichoderma Strains as Biocontrol of Fusarium oxysporum F. sp lycopersici in Tomato. J. Plant Pathol. Microbiol. 2021, 12, 571. [Google Scholar]
- Haque, Z.; Pandey, K.; Zamir, S. Bio-management of Fusarium wilt of tomato (Fusarium oxysporum f.sp. lycopersici) with multifacial Trichoderma species. Discov. Agric. 2023, 1, 7. [Google Scholar] [CrossRef]
- Meddad-Hamza, A.; Benzina, F.; Meddad, C.; Hamza, N.; Reghmit, A.; Ziane, H.; Ksentini, H. Biological control of arbuscular mycorrhizal fungi and Trichoderma harzianum against Fusarium oxysporum and Verticillium dahliae induced wilt in tomato plants. Egypt. J. Biol. Pest Control. 2023, 33, 91. [Google Scholar] [CrossRef]
- Chinheya, C.C.; Mlambo, L.C.; Shamudzarira, G.; Jere, J.; Karavina, C.; Mahere, T.; Marunda, M.; Zvobgo, G.; Dimbi, S. Evaluation of the potentials of Bacillus and Trichoderma isolates as biocontrol agents against Meloidogyne javanica and Phytophthora infestans and plant growth promoters in potatoes (Solanum tuberosum). Eur. J. Plant Pathol. 2023, 167, 699–714. [Google Scholar] [CrossRef]
- Abbod, M.; Alkhouri, I.; Shahoud, R. Investigating the effects of Trichoderma harzianum and plant compost on maize growth and Fusarium root rot management under greenhouse conditions. DYSONA-Appl. Sci. 2025, 6, 30–39. [Google Scholar] [CrossRef]
- Mitrović, I.; Čanak, P.; Živanov, S.T.; Farkaš, H.; Vasiljević, M.; Ćujić, S.; Zorić, M.; Mitrović, B. Trichoderma harzianum in biocontrol of maize fungal diseases and relevant mycotoxins: From the laboratory to the field. J. Fungi 2025, 11, 416. [Google Scholar] [CrossRef] [PubMed]
- Karuppiah, V.; He, A.; Lu, Z.; Wang, X.; Li, Y.; Chen, J. Trichoderma asperellum GDFS1009-mediated maize resistance against Fusarium graminearum stalk rot and mycotoxin degradation. Biol. Control. 2022, 174, 105026. [Google Scholar] [CrossRef]
- Iula, G.; Miras-Moreno, B.; Lucini, L.; Trevisan, M. The mycorrhiza-and Trichoderma-mediated elicitation of secondary metabolism and modulation of phytohormone profile in tomato plants. Horticulturae 2021, 7, 394. [Google Scholar] [CrossRef]
- Mendoza-Mendoza, A.; Esquivel-Naranjo, E.U.; Soth, S.; Whelan, H.; Alizadeh, H.; Echaide-Aquino, J.F.; Kandula, D.; Hampton, J.G. Uncovering the multifaceted properties of 6-pentyl-alpha-pyrone for control of plant pathogens. Front. Plant Sci. 2024, 15, 1420068. [Google Scholar] [CrossRef]
- Saldaña-Mendoza, S.A.; Pacios-Michelena, S.; Palacios-Ponce, A.S.; Chávez-González, M.L.; Aguilar, C.N. Trichoderma as a biological control agent: Mechanisms of action, benefits for crops and development of formulations. World J. Microbiol. Biotechnol. 2023, 39, 269. [Google Scholar] [CrossRef] [PubMed]
- Ferreira, N.C.D.F.; Ramos, M.L.G.; Gatto, A. Use of Trichoderma in the production of forest seedlings. Microorganisms 2024, 12, 237. [Google Scholar] [CrossRef]
- Soldan, A.; Watzlawick, L.F.; Botelho, R.V.; Faria, C.M.D.R.; Maia, A.J. Development of forestry species inoculated with Trichoderma spp. fertilized with rock phosphate. Floresta Ambiente 2018, 25, e20160643. [Google Scholar] [CrossRef]
- Nakashima, M.; Mitaka, Y.; Inagaki, T.; Matsuura, K. An antifungal compound secreted by termite workers, phenylacetic acid, inhibits the growth of both termite egg-mimicking fungus and entomopathogenic fungi. Insectes Sociaux 2024, 71, 221–232. [Google Scholar] [CrossRef]
- Ayoup, M.S.; Rabee, A.R.; Abdel-Hamid, H.; Harras, M.F.; El Menofy, N.G.; Ismail, M.M. Exploration of nitroaromatic antibiotics via Sanger’s reagent: Synthesis, in silico, and antimicrobial evaluation. ACS Omega 2022, 7, 5254–5263. [Google Scholar] [CrossRef]
- Yildirim, M.; Ozgeris, B.; Gormez, A. Substituted phenethylamine-based β-lactam derivatives: Antimicrobial, anticancer, and β-lactamase inhibitory properties. Bioorg. Chem. 2022, 129, 106212. [Google Scholar] [CrossRef]
- Webb, M.I.; Halcovitch, N.R.; Bowes, E.G.; Lee, G.M.; Geier, M.J.; Vogels, C.M.; Westcott, S.A. Arylspiroborates Derived from 4-tert-Butylcatechol and 3, 5-Di-tert-butylcatechol and Their Antimicrobial Activities. J. Heterocycl. Chem. 2014, 51, 157–161. [Google Scholar] [CrossRef]
- Mohanty, P.; Behera, S.; Behura, R.; Shubhadarshinee, L.; Mohapatra, P.; Barick, A.K.; Jali, B.R. Antibacterial activity of Thiazole and its derivatives: A. Biointerface Res. Appl. Chem. 2021, 12, 2171–2195. [Google Scholar] [CrossRef]
- Dahpour, A.A.; Rahdari, P.; Sobati, Z. Chemical composition of essential oil, antibacterial activity and brine shrimp lethality of ethanol extracts from Sedum pallidum. J. Med. Plants Res. 2012, 6, 3105–3109. [Google Scholar] [CrossRef]
- Harman, G.E.; Petzoldt, R.; Comis, A.; Chen, J. Interactions between Trichoderma harzianum strain T22 and maize inbred line Mo17 and effects of these interactions on diseases caused by Pythium ultimum and Colletotrichum graminicola. Phytopathology 2004, 94, 147–153. [Google Scholar] [CrossRef] [PubMed]
- Altomare, C.; Norvell, W.A.; Björkman, T.; Harman, G.E. Solubilization of phosphates and micronutrients by the plant-growthpromoting and biocontrol fungus Trichoderma harzianum Rifai 1295–22. Appl. Environ. Microbiol. 1999, 65, 2926–2933. [Google Scholar] [CrossRef]
- Yedidia, I.; Srivastva, A.K.; Kapulnik, Y.; Chet, I. Effect of Trichoderma harzianum on microelement concentrations and increased growth of cucumber plants. Plant Soil 2001, 235, 235–242. [Google Scholar] [CrossRef]

| Morphology and Microscopic Features | Trichoderma Species on MEA | Trichoderma Species on PDA | ||
|---|---|---|---|---|
| T. afroharzianum | T. longibrachiatum | T. afroharzianum | T. longibrachiatum | |
| Colony appearance | White mycelium colony with greenish ring at center or edges | Gray greenish, sometimes white mycelium with greenish ends | White aerial mycelium with ring and greenish and cottony colony, or white and sparse or grayish green aerial mycelium | Greenish in two rings or one, white mycelium rarely formed, or gray greenish colony in one ring with abundant appearance, rarely produced yellow pigmentation around colony |
| Conidia width (µm) | 2.45–3.63 | 2.32–3.28 | 2.35–2.73 | 2.25–3.76 |
| Conidia length (µm) | 2.93–7.58 | 2.87–9.42 | 2.83–5.75 | 2.6–4.89 |
| Conidia shape | Ovate, sub-globose and globose abundant, ellipsoidal rare, smooth | Ellipsoidal-to-ovate abundant, globose rare, smooth. | Ovate, sub-globose and globose abundant, ellipsoidal rare, smooth. | Ellipsoidal-to-ovate abundant, smooth |
| Shape of phialides | Ampuliform | Lageniform | Ampuliform | Lageniform |
| Chlamydospores | Present | Absent | Rarely formed | Absent |
| Strain Code | Species Name | Source of Isolate | Inhibition% (Mean ± SD, no. = 3) |
|---|---|---|---|
| AEMCTa2 | T. afroharzianum | Maize seeds, Egypt | 47.65 * ± 14.05 |
| AEMCTa3 | T. afroharzianum | Soil, Italy | 100 * ± 0 |
| AEMCTa5 | T. afroharzianum | Soil, Italy | 52.55 * ± 10.75 |
| AEMCTa6 | T. afroharzianum | Soil, Italy | 100 * ± 0 |
| AEMCTl8 | T. longibrachiatum | Maize seeds, Egypt | 53.75 * ± 18.45 |
| AEMCTl9 | T. longibrachiatum | Maize seeds, Egypt | 56.6 * ± 17.3 |
| AEMCTl10 | T. longibrachiatum | Maize seeds, Egypt | 55.5 * ± 11.2 |
| AEMCTl11 | T. longibrachiatum | Maize roots, Egypt | 62.15 * ± 7.25 |
| AEMCTl12 | T. longibrachiatum | Maize seeds, Egypt | 68.9 * ± 1.7 |
| AEMCTl13 | T. longibrachiatum | Soil, Egypt | 63.7 * ± 3 |
| AEMCTl14 | T. longibrachiatum | Maize seeds, Egypt | 52.35 * ± 18.75 |
| AEMCTl1 | T. longibrachiatum | Maize seeds, Egypt | 66.45 * ± 5.75 |
| AEMCTl15 | T. longibrachiatum | Maize seeds, Egypt | 60.6 * ± 15.5 |
| AEMCTl4 | T. longibrachiatum | Lemon fruit, Egypt | 62.8 * ± 12.8 |
| AEMCTl16 | T. longibrachiatum | Maize seeds, Egypt | 58.35 * ± 11.65 |
| AEMCTl17 | T. longibrachiatum | Lemon fruit, Egypt | 62.75 * ± 7.85 |
| AEMCTl18 | T. longibrachiatum | Maize seeds, Egypt | 61.35 * ± 4.75 |
| AEMCTl19 | T. longibrachiatum | Grape vine, Egypt | 56.55 * ± 7.35 |
| AEMCTl20 | T. longibrachiatum | Grape vine, Egypt | 49.5 * ± 21.6 |
| AEMCTl7 | T. longibrachiatum | Grape vine, Egypt | 63.55 * ± 5.35 |
| Treatments | Treatment Details | Disease Incidence | Fresh Weight (g) | Dry Weight (g) | ||
|---|---|---|---|---|---|---|
| Shoot | Root | Shoot | Root | |||
| T1 | Soil without fungal inoculum | 0 ± 0 a | 10.59 ± 2.51 a | 6.70 ± 1.06 b | 1.245 ± 0.28 b | 1.02 ± 0.18 b |
| T2 | Soil with 0.2% T. afroharzianum AEMCTa3 | 5.55 ± 5.6 b | 9.63 ± 1.07 a | 7.58 ± 0.84 c | 1.39 ± 0.16 c | 1.15 ± 0.12 c |
| T3 | Soil with 0.2% T. afroharzianum AEMCTa6 | 0 ± 0 a | 14.55 ± 1.33 b | 12.04 ± 1.09 f | 1.68 ± 0.15 d | 1.71 ± 0.15 e |
| T4 | Soil with 1% F. proliferatum | 50 ± 16.66 d | 8.57 ± 0.95 a | 5.76 ± 0.64 a | 0.93 ± 0.10 a | 0.78 ± 0.08 a |
| T5 | Soil with 1% F. proliferatum + 0.2% afroharzianum AEMCTa3 | 16.66 ± 0 c | 16.08 ± 1.79 bc | 11.28 ± 1.25 e | 1.763 ± 0.19 e | 2.18 ± 0.24 f |
| T6 | Soil with 1% F. proliferatum + 0.2% T. afroharzianum AEMCTa6 | 0 ± 0 a | 17.45 ± 1.94 c | 9.43 ± 1.05 d | 1.94 ± 0.21 f | 1.55 ± 0.17 d |
| Compound No. | Analyte/Parameter | AEMCTa3 Description | AEMCTa6 Description | Activity |
|---|---|---|---|---|
| 1 | 1-Hydroxy-4-Nitrobenzene | - | Value: 0.943% Retention time: 56.313 min | A |
| 2 | 2-Butyl-3a,4,7,7a-tetrahydro-1H-isoindole-1,3(2 H)-dione | - | Value: 0.016% Retention time: 82.537 min | - |
| 3 | 2-Oxo-4-Nitrosomethyl-6-Trifluoro-Methyl-1,2-D ihydropyrimidine | - | Value: 0.779% Retention time: 83.585 min | - |
| 4 | 4-(3-Chloro-4-Morpholin-4-Yl-Phenyl)-1-(4-Chlo ro-Phenyl)-5-(3,4-Dimethoxy-Phenyl)-4,5-Dihyd ro-1h-[1,2,4]Triazole-3-Carboxylic Acid Ethyl Ester | - | Value: 1.884% Retention time: 26.208 min | - |
| 5 | 6-Ethyl-2,3-dihydro-2,7-dimethyl-5-oxo-5H-Oxa zolo [3,2-a]pyridine-8-carbonitrile | - | Value: 0.248% Retention time: 44.702 min | - |
| 6 | 9,10-Dehydro-6-Desoxy-Indolinocodeine | - | Value: 1.004% Retention time: 56.785 min | - |
| 7 | Beta.-Dihydroagarofuran | - | Value: 0.411% Retention time: 52.167 min | - |
| 8 | Decane | - | Value: 0.466% Retention time: 16.667 min | - |
| 9 | Ethanediimidic Acid Dihydrazide | - | Value: 1.228% Retention time: 41.105 min | - |
| 10 | Heptadecane | - | Value: 0.724% Retention time: 60.110 min | - |
| 11 | Pentadecane | - | Value: 0.353% Retention time: 58.163 min | - |
| 12 | Tetracosane | - | Value: 0.466% Retention time: 46.067 min | - |
| 13 | Triacontane | - | Value: 0.693% Retention time: 55.983 min | - |
| 14 | 5-(1,3,5-trimethyl-4-pyrazolyl)amino-1,2,4-Triaz ol-3-amine | Value: 1.125% Retention time: 63.922 min | - | - |
| 15 | (.+.)-1,4,5,6,7,8-hexahydro-6,6,7,7,8,8-hexam ethyl-2,4-diphenyl-2H-cyclopent[D][1,2]oxazepi ne | Value: 0.382% Retention time: 62.913 min | - | - |
| 16 | (+)-5-(1-Acetoxy-1-methylethyl)-2-methyl-2-cy clohexen-1-one semicarbazone | Value: 0.417% Retention time: 53.967 min | - | - |
| 17 | (5,10)-(7,8)-Dioxirane derivative of .alpha.-4-phenyl-1,2,4-triazolin-3,5-dione adduct of vitamin d3 (Isomer A) | Value: 0.592% Retention time: 65.128 min | - | - |
| 18 | (5,10)-(7,8)-Dioxirane derivative of .alpha.-4-phenyl-1,2,4-triazolin-3,5-dione adduct of vitamin d3 (Isomer B) | Value: 0.256% Retention time: 46.302 min | - | - |
| 19 | (5-Ethoxycarbonylamino-2,6-dimethylpyridin-3- yl)carbamic acid, ethyl ester | Value: 0.256% Retention time: 46.602 min | - | - |
| 20 | 1-(2-Chlorophenyl)-1,2,3,4-tetrahydro-3-metho xycarbonyl-9H-indolo[2,3-c]pyridine | Value: 1.644% Retention time: 65.806 min | - | - |
| 21 | 1-(3-Methylphenyl)-1H-Indole | Value: 1.328% Retention time: 63.663 min | - | P |
| 22 | 1-(4-Methyl-2-[(trimethylsilyl)oxy]phenyl)ethano ne | Value: 1.159% Retention time: 60.038 min | Value: 0.410% Retention time: 96.684 min | - |
| 23 | 1-(5-Methyl-2-[(Trimethylsilyl)Oxy]Phenyl)Etha none | Value: 1.658% Retention time: 71.188 min | - | - |
| 24 | 1-Methyl-3-phenylindole | Value: 0.273% Retention time: 52.178 min | - | P |
| 25 | 2-(5-Adamantan-1-yl-[1,2,4]oxadiazol-3-yl)-pyri dine | Value: 0.232% Retention time: 47.923 min | Value: 0.058% Retention time: 71.443 min | - |
| 26 | 2,4-Dimethylbenzo[h]quinoline | Value: 1.004% Retention time: 77.869 min | - | - |
| 27 | 2-Amino-4,4,6,6-tetramethyl-4,6-dihydro-thieno [2,3-c]furan-3-carbonitrile | Value: 1.658% Retention time: 48.985 min | - | - |
| 28 | 2-Chloro-2-Phenylethylamine | Value: 0.749% Retention time: 67.672 min | - | A |
| 29 | 2-Phenyl-N-methylindole | Value: 1.506% Retention time: 59.547 min | - | P |
| 30 | 3,5-Dimethyl-2,6-bis(trimethylsiloxy)pyridine | Value: 1.189% Retention time: 68.454 min | - | - |
| 31 | 3,5-Ditert-Butyl-4-Hydroxy-2,4-Cyclohexadien- 1-One | Value: 1.129% Retention time: 72.967 min | - | - |
| 32 | 3,5-di-tert-Butylcatechol | Value: 0.354% Retention time: 66.431 min | Value: 0.115% Retention time: 97.732 min | A |
| 33 | 3-Amino-2-Hydroxy-5-Sulfobenzoic Acid | Value: 1.157% Retention time: 75.817 min | - | - |
| 34 | 3-Methyl-2-Phenyl-1H-Indole | Value: 0.259% Retention time: 45.514 min | - | P |
| 35 | 4-[[4-(4-Bromo-Phenyl)-Thiazol-2-Yl]-Methyl-A mino]-Butyric Acid | Value: 6.944% Retention time: 69.462 min | Value: 0.051% Retention time: 82.472 | A |
| 36 | 4-Chloro-2-trifluoromethylbenzo[h]quinoline | Value: 0.885% Retention time: 79.213 min | - | - |
| 37 | 5-(p-Aminophenyl)-4-(p-tolyl)-2-thiazolamine | Value: 0.654% Retention time: 62.095 min | - | - |
| 38 | 5,5′,6,6′,8,8′-Hexamethoxy-2,2′-Dimethyl-[9,9′-Bi-4h-Naphtho[2,3-B]Pyran]-4,4′-Dione | Value: 1.380% Retention time: 75.115 min | - | - |
| 39 | 6-Amyl .Alpha. Pyrone | Value: 1.552% Retention time: 64.814 min | Value: 35.552% Retention time: 42.412 min | P |
| 40 | 8,11-Epoxy-9,12-Ethano-11,15-Methano-11h-[1,8]Dioxacycloheptadecino[4,3-b]Pyridine, Evonine deriv. | Value: 0.371% Retention time: 56.772 min | - | - |
| 41 | 8-Methylisothiazolo[4,5-C]-2,1,3-Benzothiadiaz ole | Value: 1.544% Retention time: 69.840 min | Value: 0.065% Retention time: 81.903 min | - |
| 42 | Gibberellique Acid | Value: 26.420% Retention time: 42.399 min | Value: 10.760% Retention time: 96.496 min | P |
| 43 | Indolo[2,3-a]quinolizine, 17-norcorynan-18-carboxylic acid deriv. | Value: 0.287% Retention time: 78.887 min | - | P |
| 44 | N-ethyl-1,3-dithioisoindoline | Value: 0.259% Retention time: 47.244 min | Value: 0.304% Retention time: 83.145 min | A |
| 45 | Phenylacetic acid, 2-(1-adamantyl)ethyl ester | Value: 0.526% Retention time: 78.222 min | Value: 0.380% Retention time: 84.102 min | P |
Disclaimer/Publisher’s Note: The statements, opinions and data contained in all publications are solely those of the individual author(s) and contributor(s) and not of MDPI and/or the editor(s). MDPI and/or the editor(s) disclaim responsibility for any injury to people or property resulting from any ideas, methods, instructions or products referred to in the content. |
© 2025 by the authors. Licensee MDPI, Basel, Switzerland. This article is an open access article distributed under the terms and conditions of the Creative Commons Attribution (CC BY) license (https://creativecommons.org/licenses/by/4.0/).
Share and Cite
El-Dawy, E.G.A.M.; Gherbawy, Y.A.; Ioan, P.; Hussein, M.A. Identification of Trichoderma spp., Their Biomanagement Against Fusarium proliferatum, and Growth Promotion of Zea mays. J. Fungi 2025, 11, 683. https://doi.org/10.3390/jof11090683
El-Dawy EGAM, Gherbawy YA, Ioan P, Hussein MA. Identification of Trichoderma spp., Their Biomanagement Against Fusarium proliferatum, and Growth Promotion of Zea mays. Journal of Fungi. 2025; 11(9):683. https://doi.org/10.3390/jof11090683
Chicago/Turabian StyleEl-Dawy, Eman G. A. M., Youssuf A. Gherbawy, Pet Ioan, and Mohamed A. Hussein. 2025. "Identification of Trichoderma spp., Their Biomanagement Against Fusarium proliferatum, and Growth Promotion of Zea mays" Journal of Fungi 11, no. 9: 683. https://doi.org/10.3390/jof11090683
APA StyleEl-Dawy, E. G. A. M., Gherbawy, Y. A., Ioan, P., & Hussein, M. A. (2025). Identification of Trichoderma spp., Their Biomanagement Against Fusarium proliferatum, and Growth Promotion of Zea mays. Journal of Fungi, 11(9), 683. https://doi.org/10.3390/jof11090683

